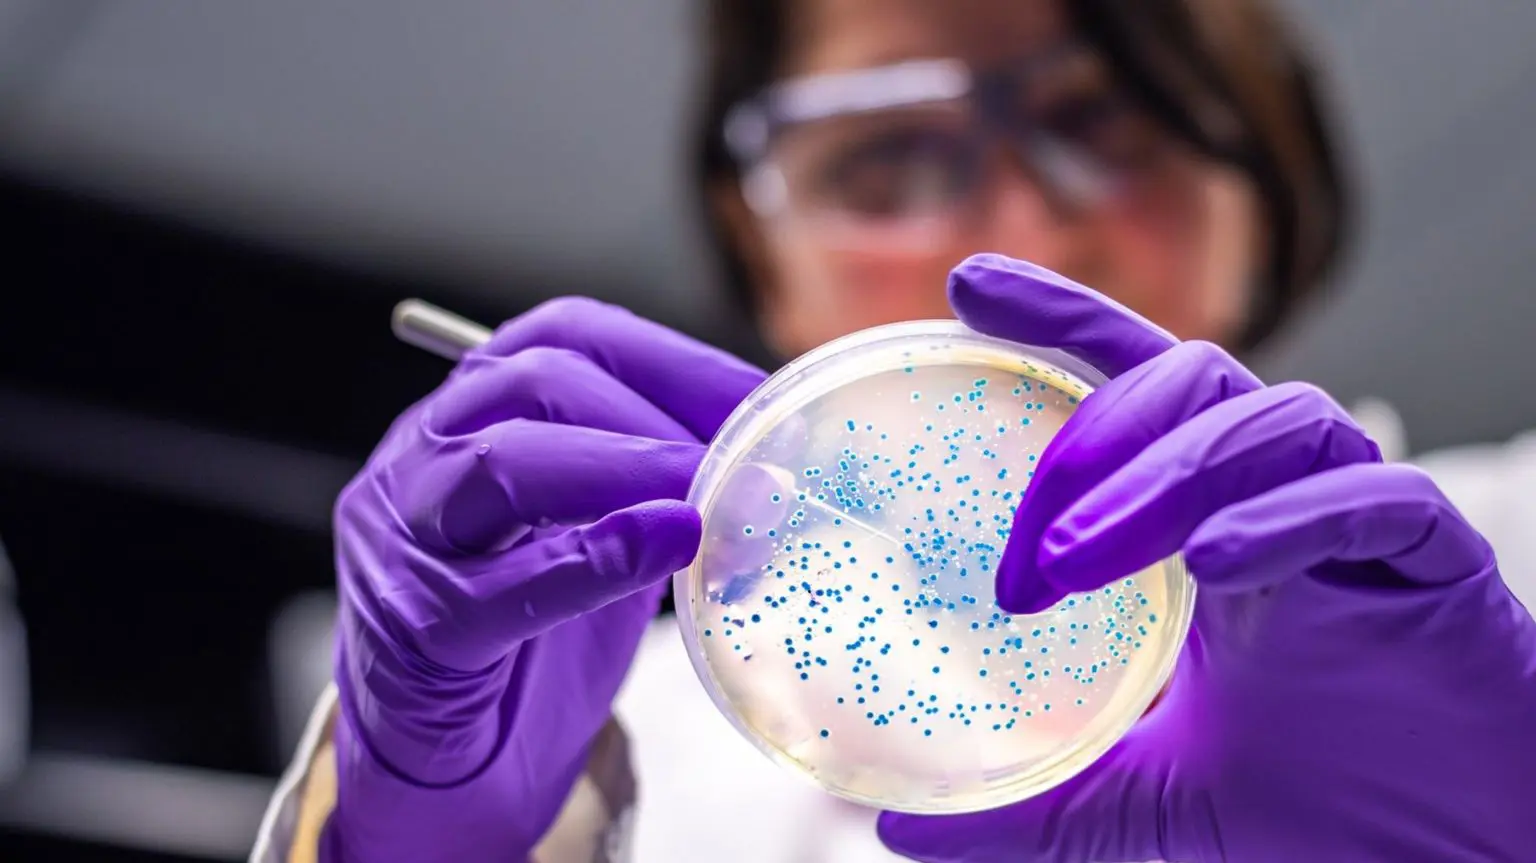

Ранее в этом году новый необычный способ использования пластиковых отходов попал в заголовки газет.
Обычную бактерию генетически модифицировали так, чтобы она поедала молекулу, полученную из пластика, а затем переваривала её, производя привычное обезболивающее — парацетамол.
Микроб, использованный Стивеном Уоллесом, профессором химической биотехнологии Эдинбургского университета, — это Escherichia coli, более известная как E. coli.
Эта палочковидная бактерия обитает в кишечнике человека и животных и, возможно, вам больше знакома как неприятный микроб, способный вызывать заболевания.
Профессор Уоллес выбрал её неслучайно, поскольку определённые штаммы E. coli, не являющиеся патогенными, широко используются в биотехнологических и инженерно-биологических лабораториях для проверки эффективности того или иного препарата.
E. coli — главная «рабочая лошадка» в этой области, говорит профессор Уоллес, который также генетически модифицировал её в лабораторных условиях, чтобы превратить пластиковые отходы в ванильный ароматизатор, а жирные отходы из канализации — в духи.
«Если вы хотите доказать, что что-то возможно в биологии, E. coli — это естественная первая ступень», — говорит он.
Использование этого микроба не ограничивается лабораторными исследованиями. В промышленности резервуары с генетически модифицированной E. coli действуют как живые фабрики, производя самые разные продукты: от фармацевтических препаратов, таких как инсулин, жизненно важный для лечения диабета, до различных химических веществ, используемых для производства топлива и растворителей.
Но как E. coli стала такой важной опорой биотехнологии, почему она так полезна и что может ожидать её в будущем?
Доминирование E. coli обусловлено её ролью модельного организма для понимания общих биологических принципов, говорит Томас Силхави, профессор молекулярной биологии Принстонского университета, который изучает эту бактерию уже около 50 лет и документирует её историю.
Среди других известных модельных организмов — мыши, плодовые мушки и пекарские дрожжи. Дрожжи, как и E. coli, также стали бесценным инструментом в биотехнологии, как в лабораторных условиях, так и в промышленности, но у них более сложная структура клеток и разнообразные области применения.
E. coli была впервые выделена в 1885 году немецким педиатром Теодором Эшерихом, изучавшим кишечную микрофлору младенцев. Благодаря быстрому росту и простоте работы с ней, учёные начали использовать её для изучения базовой биологии бактерий.
Затем, в 1940-х годах, «счастливая случайность» вывела её на новый уровень, говорит профессор Силхави.
Непатогенный штамм E. coli (K-12) был использован для демонстрации того, что бактерии не просто делятся, но и способны к «бактериальному спариванию», в ходе которого они обмениваются генами и рекомбинируют, приобретая новые свойства.
Это было эпохальное открытие, и E. coli стала «всеобщим любимцем», говорит он.
Благодаря этому E. coli сыграла ключевую роль во многих других открытиях и важных этапах в генетике и молекулярной биологии.
Её использовали для расшифровки генетического кода, а в 1970-х годах она стала первым организмом, созданным с помощью генной инженерии путём введения в неё чужеродной ДНК, что заложило основу для современной биотехнологии.
Это также решило проблему с выработкой инсулина. Инсулин, получаемый из крупного рогатого скота и свиней, использовался для лечения диабета, но вызывал аллергические реакции у некоторых пациентов.
Однако в 1978 году с использованием E. coli был получен первый синтетический человеческий инсулин, что стало огромным прорывом.
В 1997 году E. coli стала одним из первых организмов, чей геном был полностью секвенирован, что упростило его изучение и работу с ним.
Адам Фейст, профессор Калифорнийского университета в Сан-Диего, занимающийся разработкой микроорганизмов для промышленного применения, говорит, что ценит E. coli за её многочисленные полезные свойства.
Помимо обширных знаний о её генетике и инструментов, упрощающих её конструирование, эта бактерия быстро и предсказуемо растёт на самых разных субстратах. Она не «капризна», как некоторые другие, её можно без проблем замораживать и восстанавливать, и она необычайно хорошо приживается с чужеродной ДНК.
«Чем больше я работаю с микроорганизмами, тем больше я понимаю, насколько устойчива кишечная палочка», — говорит он.
Синтия Коллинз — старший директор компании Ginkgo Bioworks, которая помогает компаниям разрабатывать биотехнологическую продукцию, и помогла им внедрить промышленное использование кишечной палочки.
Хотя выбор микроорганизмов, доступных для крупномасштабного производства, несколько шире, чем несколько десятилетий назад, когда кишечная палочка часто была единственным выбором, она всё ещё может быть «хорошим выбором» в зависимости от продукта, говорит доктор Коллинз. (Даже при самых интенсивных биоинженерных технологиях кишечная палочка не способна производить всё).
«Это очень экономично; можно откачать много», — говорит она, отмечая, что если бактерия производит что-то токсичное для клеток, толерантность часто можно выработать.
Однако есть и те, кто задаётся вопросом, не мешает ли нам доминирование E. coli находить наилучшие биотехнологические решения для наших проблем.
Пол Дженсен, микробиолог и инженер из Мичиганского университета, изучает бактерии, живущие у нас во рту. Недавно он проанализировал, насколько мало изучены большинство других бактерий по сравнению с кишечной палочкой.
Он считает, что, пока мы продолжаем активно разрабатывать E. coli для создания выдающихся возможностей, могут существовать и другие микробы, которые делают то же самое естественным образом – и даже лучше – но которые остаются незамеченными, и мы упускаем возможность извлечь из них пользу, поскольку их не ищут и не изучают.
Например, биоразведка на свалках может обнаружить микробов, которые начали питаться не только пластиком, но и другими видами отходов, говорит он. И, возможно, существуют бактерии, которые делают то, что мы даже не могли себе представить, например, производят цемент или резину. Он отмечает, что бактерии, живущие у нас во рту, превосходят кишечную палочку по кислотоустойчивости.
«Мы настолько глубоко изучили E. coli, что не уделяем этому достаточного внимания», — говорит он.
Существуют альтернативные варианты, над которыми работают, чтобы расширить возможности, включая Vibrio natriegens (V. nat), который начал привлекать внимание как потенциальный конкурент E. coli.
V. nat был впервые выделен из солончака в американском штате Джорджия ещё в 1960-х годах, но оставался практически без внимания в коллекциях культур и морозильниках до середины 2010-х годов, когда была отмечена его сверхбыстрая скорость роста — вдвое выше, чем у E. coli, — что может стать значительным промышленным преимуществом.
Кроме того, он гораздо эффективнее поглощает чужеродную ДНК, говорит Баз Барстоу, инженер-биолог и эколог из Корнеллского университета, один из разработчиков этого микроорганизма. Он говорит, что его возможности по сравнению с E. coli можно сравнить с «переходом с лошади на автомобиль».
Доктор Барстоу фокусируется на V. nat, стремясь увидеть микробы, используемые для решения серьёзных задач устойчивого развития — от производства реактивного топлива из углекислого газа и зелёной электроэнергии до добычи редкоземельных металлов. «Проще говоря, E. coli не поможет нам реализовать ни одну из этих целей. V. natriegens — возможно», — говорит он.
В этом году его лаборатория основала компанию Forage Evolution, которая разрабатывает инструменты, упрощающие для исследователей его лабораторную модификацию.
Профессор Фейст признаёт, что V. nat обладает привлекательными свойствами, но генетические инструменты, необходимые для широкого применения, пока отсутствуют, и ему ещё предстоит доказать свою эффективность в больших масштабах. «E. coli сложно заменить», — говорит он.